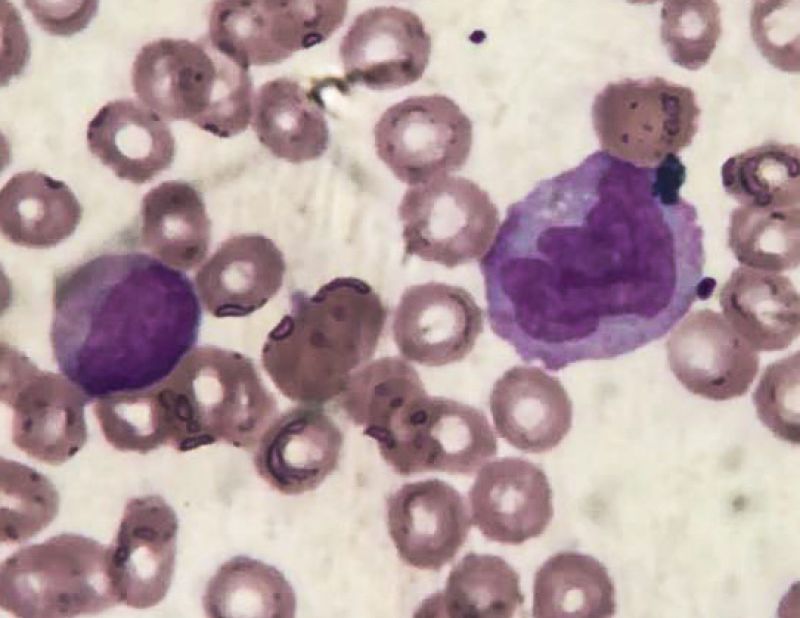

SMD em tranformação

Nem sempre o churrasco está na churrascaria!!!
Esse caso clínico comprova que nem sempre os quadros complicados hematológicos são descobertos em pacientes com sintomatologia característica. As vezes a situação vem de onde menos esperamos!!!
Paciente 23 anos, masculino, em acompanhamento com Tricologista. Sem sintomas aparentes.
Hemograma:
Eri: 2,69 / Hb: 9,0 / VG: 26,8 / VCM: 99,6 / HCM: 33,5 / CHCM: 33,6 / RDW: 16,8
Plaquetas: 125.000
Dif. Aparelho:
Neut: 29,7 / Linf: 18,2 / mono: 39,1 / eo: 0,05 / baso: 0,12 / IG: 12,3
A lâmina chega a nos assustar pela morfologia dos monócitos. São praticamente todos com tamanho aumentado e alto pleomorfismo nuclear. Também encontra-se muitos granulócitos com assincronismo de maturação, além de blastos.
O diferencial manual:
Blasto: 13 / promonócito: 2 / monócito: 29 / mielócito: 2 / metamielocito: 2 / bastonete: 5 / segmentado: 27 / linfócito: 18 / linfócito reativo: 2
VEJA AS FOTOS!
As observações do laudo:
- Presença de vários monócitos anômalos, com tamanho aumentado e intenso pleomorfismo nuclear.
- Presença de assincronismo maturativo na linhagem neutrofílica.
- Blastos de tamanho grande, moderada relação N/C, núcleo com cromatina frouxa, nucléolos evidentes, citoplasma levemente basofílico, alguns com intensa granulação.
- Presença de 4 eritroblastos em 100 células contadas.
- Policromasia moderada
Um caso que assusta pela quantidade de blastos, que, em uma coloração ruim ou com algum analista inseguro, poderia passar batido, e o diagnóstico ser negligenciado. Quando alguma coisa parece estranha na lâmina, ela é estranha!
Esses sinais de displasia levam a pensar em uma Síndrome Mielo Displásica, e essa quantidade de blastos faz pensar em uma SMD em transformação para Leucemia Mielóide Aguda, provavelmente m4 (que é uma SMD), ou m5, pensando na quantidade e morfologia de monócitos.
A mielodisplasia tem essa característica. Assincronismo, maturação anômala, células com morfologia esquisita, estranha aos nossos olhos. Um hemograma bem feito é o diferencial tanto no diagnóstico quanto no acompanhamento do paciente.
Veja que as observações do hemograma são objetivas. Ninguém falou sobre a anemia ou leucocitose, visto que os números já falam sobre isso!
Esse caso clínico comprova que nem sempre os quadros complicados hematológicos são descobertos em pacientes com sintomatologia característica. As vezes a situação vem de onde menos esperamos!!!
Paciente 23 anos, masculino, em acompanhamento com Tricologista. Sem sintomas aparentes.
Hemograma:
Eri: 2,69 / Hb: 9,0 / VG: 26,8 / VCM: 99,6 / HCM: 33,5 / CHCM: 33,6 / RDW: 16,8
Plaquetas: 125.000
Dif. Aparelho:
Neut: 29,7 / Linf: 18,2 / mono: 39,1 / eo: 0,05 / baso: 0,12 / IG: 12,3
A lâmina chega a nos assustar pela morfologia dos monócitos. São praticamente todos com tamanho aumentado e alto pleomorfismo nuclear. Também encontra-se muitos granulócitos com assincronismo de maturação, além de blastos.
O diferencial manual:
Blasto: 13 / promonócito: 2 / monócito: 29 / mielócito: 2 / metamielocito: 2 / bastonete: 5 / segmentado: 27 / linfócito: 18 / linfócito reativo: 2
VEJA AS FOTOS!
As observações do laudo:
- Presença de vários monócitos anômalos, com tamanho aumentado e intenso pleomorfismo nuclear.
- Presença de assincronismo maturativo na linhagem neutrofílica.
- Blastos de tamanho grande, moderada relação N/C, núcleo com cromatina frouxa, nucléolos evidentes, citoplasma levemente basofílico, alguns com intensa granulação.
- Presença de 4 eritroblastos em 100 células contadas.
- Policromasia moderada
Um caso que assusta pela quantidade de blastos, que, em uma coloração ruim ou com algum analista inseguro, poderia passar batido, e o diagnóstico ser negligenciado. Quando alguma coisa parece estranha na lâmina, ela é estranha!
Esses sinais de displasia levam a pensar em uma Síndrome Mielo Displásica, e essa quantidade de blastos faz pensar em uma SMD em transformação para Leucemia Mielóide Aguda, provavelmente m4 (que é uma SMD), ou m5, pensando na quantidade e morfologia de monócitos.
A mielodisplasia tem essa característica. Assincronismo, maturação anômala, células com morfologia esquisita, estranha aos nossos olhos. Um hemograma bem feito é o diferencial tanto no diagnóstico quanto no acompanhamento do paciente.
Veja que as observações do hemograma são objetivas. Ninguém falou sobre a anemia ou leucocitose, visto que os números já falam sobre isso!
Gostou do nosso conteúdo?
Cadastre-se para receber nossos conteúdos exclusivos.